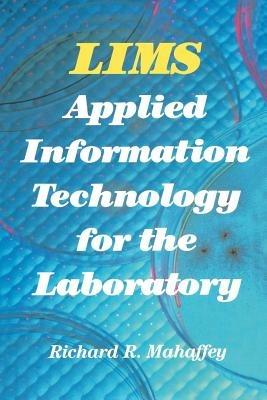
LIMS: Applied Information Technology for the Laboratory - Richard Mahaffey - cover

L’articolo è stato aggiunto alla lista dei desideri
IBS.it, l'altro eCommerce
LIMS: Applied Information Technology for the Laboratory
Cliccando su “Conferma” dichiari che il contenuto da te inserito è conforme alle Condizioni Generali d’Uso del Sito ed alle Linee Guida sui Contenuti Vietati. Puoi rileggere e modificare e successivamente confermare il tuo contenuto. Tra poche ore lo troverai online (in caso contrario verifica la conformità del contenuto alle policy del Sito).
Grazie per la tua recensione!
Tra poche ore la vedrai online (in caso contrario verifica la conformità del testo alle nostre linee guida). Dopo la pubblicazione per te +4 punti
Altre offerte vendute e spedite dai nostri venditori



Tutti i formati ed edizioni
Promo attive (0)
Computing and information management technologies touch our lives in the environments where we live, play and, work. High tech is becoming the standard. Those of use who work in a laboratory environment are faced with an obvious challenge. How do we best apply these technol ogies to make money for our companies? The first level of deliverable benefits is achieved through task automation. The second level is ob tained by integrating the individual islands of automation. The third, or top level, of benefits is related to applying intelligence to computing applications. The use of computing technology, at level one, to automate lab pro cedures, methods, and instruments has been profitable for many years. We can easily find yearly returns in the range of 10-50% for investments at this level. For level two, the integration of some applications has evolved and has led to data management systems and local area net working in the lab environment. Investment paybacks at level two are substantially higher, in the range of 200-400%. Examples of applications at the top level, that of intelligent systems and applications, are few and far between. And what about the payback for investments at this level? With such limited experience at level three, we can only estimate the benefits. But again, they appear to be much higher, in the range of 2000- 4000%.
L'articolo è stato aggiunto al carrello
Le schede prodotto sono aggiornate in conformità al Regolamento UE 988/2023. Laddove ci fossero taluni dati non disponibili per ragioni indipendenti da IBS, vi informiamo che stiamo compiendo ogni ragionevole sforzo per inserirli. Vi invitiamo a controllare periodicamente il sito www.ibs.it per eventuali novità e aggiornamenti.
Per le vendite di prodotti da terze parti, ciascun venditore si assume la piena e diretta responsabilità per la commercializzazione del prodotto e per la sua conformità al Regolamento UE 988/2023, nonché alle normative nazionali ed europee vigenti.
Per informazioni sulla sicurezza dei prodotti, contattare productsafetyibs@feltrinelli.it
L’articolo è stato aggiunto alla lista dei desideri